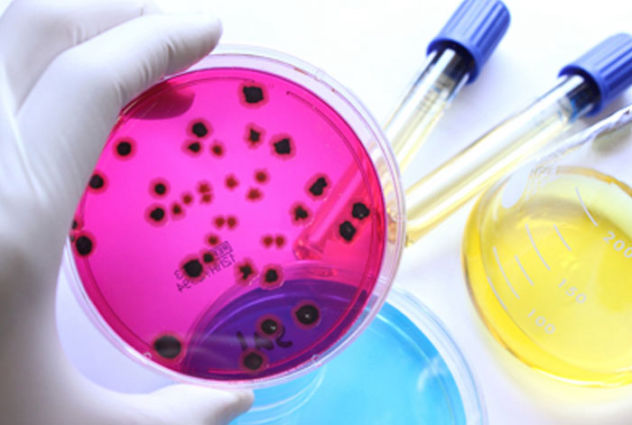

Contamos con un sin número de productos de excelente calidad para limpieza de maquinarias, grasas, aceites, etc.

Cumple con los estándares de calidad y servicio para lo cual contamos con una gran variedad de productos para este propósito

Desarrollamos una variedad de productos necesarios, para el área hospitalaria, con una calidad al 100% de concentración y efectividad.

Consideramos de mucha importancia, resaltar nuestros productos, que cumplen normas establecidas para cada propósito.

Consideramos la importancia de fabricar, productos eficaces, para la limpieza y mantenimiento del sector agrícola
Representamos a nivel nacional, con nuestros productos, a varios sectores de la producción como: bananeras, camaroneras empresas de alcantarillado y otros inmersos en el consumo de bacterias microbiológicas.

Consideramos la importancia de fabricar, productos para la limpieza y mantenimiento del sector petrolero.

Contamos con una gama completa de productos para limpieza textil, siendo aceptados por parte de la industria manufacturera textil

O ven y toma café en un lugar cómodo y pasa el rato con nosotros.
Guayaquil - Ecuador
Francisco de Marcos # 330 y Chimborazo
Quinto piso, Oficina 5-C
Islas Galápagos - Ecuador
Av. Baltra nro. 294 y 10 de Marzo - Santa Cruz
Mail: info@latitudcorp.com
Teléfonos:
(593)-4-2401084
(593)-99-448-9870
Lunes —Viernes
9:30 am — 5:30 pm
O envíanos un mensaje:
SÍGUENOS EN LAS REDES!